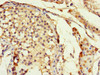

Cusabio Polyclonal Antibodies
DLX5 Antibody | CSB-PA006956LA01HU
- SKU:
- CSB-PA006956LA01HU
- Availability:
- 3 to 7 Working Days
Description
DLX5 Antibody | CSB-PA006956LA01HU | Cusabio
DLX5 Antibody is Available at Gentaur Genprice with the fastest delivery.
Online Order Payment is possible or send quotation to info@gentaur.com.
Product Type: Polyclonal Antibody
Target Names: DLX5
Aliases: Homeobox protein DLX-5, DLX5
Background: Transcriptional factor involved in bone development. Acts as an immediate early BMP-responsive transcriptional activator essential for osteoblast differentiation. Stimulates ALPL promoter activity in a RUNX2-independent manner during osteoblast differentiation. Stimulates SP7 promoter activity during osteoblast differentiation. Promotes cell proliferation by up-regulating MYC promoter activity. Involved as a positive regulator of both chondrogenesis and chondrocyte hypertrophy in the endochondral skeleton. Binds to the homeodomain-response element of the ALPL and SP7 promoter. Binds to the MYC promoter. Requires the 5'-TAATTA-3' consensus sequence for DNA-binding.
Isotype: IgG
Conjugate: Non-conjugated
Clonality: Polyclonal
Uniport ID: P56178
Host Species: Rabbit
Species Reactivity: Human
Immunogen: Recombinant Human Homeobox protein DLX-5 protein (1-249AA)
Immunogen Species: Human
Applications: ELISA, IHC, IF
Tested Applications: ELISA, IHC, IF; Recommended dilution: IHC:1:20-1:200, IF:1:50-1:200
Purification Method: >95%, Protein G purified
Dilution Ratio1: ELISA:1:2000-1:10000
Dilution Ratio2: IHC:1:20-1:200
Dilution Ratio3: IF:1:50-1:200
Dilution Ratio4:
Dilution Ratio5:
Dilution Ratio6:
Buffer: Preservative: 0.03% Proclin 300
Constituents: 50% Glycerol, 0.01M PBS, PH 7.4
Form: Liquid
Storage: Upon receipt, store at -20°C or -80°C. Avoid repeated freeze.
Initial Research Areas: Neuroscience
Research Areas: Epigenetics & Nuclear Signaling;Neuroscience;Signal transduction;Stem cells